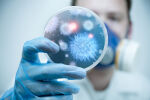
Ангел Кунчев: Тази година грипът е с променен генетичен код и нямаме обществен имунитет

След като във Варна бяха въведени противоепидемични мерки заради пика на заболелите от грип, Бургас вече е в предепидемична обстановка.
Здравните власти отчитат увеличение на пациентите с тежки усложнения и предупреждават, че до края на седмицата е възможно обявяване на грипна епидемия и в други области – сред тях Добрич, Силистра, Хасково и Смолян. Ръст на заболелите има и в Перник и Ямбол.
По данни на здравните институции общата заболеваемост за страната е 133 на 10 000 души, а за София – 64 на 10 000.
За превенцията и лечението на грипа в предаването „Тази сутрин“ на bTV говори д-р Ина Детелинова, общопрактикуващ лекар в София.
По думите ѝ основният симптом при грип А и Б е високата температура – около 39 градуса, която трудно се повлиява от медикаменти. Често са налице и мускулни болки, кашлица и хрема.
Най-голямата опасност обаче са усложненията – особено при деца под 2-годишна възраст и възрастни над 65 години с хронични заболявания. Сред тях са бронхиолит, остър бронхит, пневмония, а в най-тежките случаи – дихателна недостатъчност.
Д-р Детелинова категорично предупреждава да не се прибягва до самолечение, особено ако симптомите се проявяват повече от три дни. Това може да доведе до сериозни усложнения.
Нейният основен съвет е още в първите 24 часа от появата на симптоми да се направи тест за грип и COVID-19, за да се приложи навременно и таргетно лечение.
Най-уязвими са малките деца под 3-годишна възраст, кърмачетата, както и възрастните хора с хронични заболявания. При тях родителите и близките трябва да бъдат особено бдителни още в първите часове на заболяването.
Сред основните превантивни мерки лекарите посочват носенето на маски в градския транспорт, големите магазини и други обществени места, редовното проветряване на помещенията, честото миене на ръцете и спазването на добра лична хигиена. В редица медицински центрове носенето на маски вече е задължително.
Лекарите припомнят – ранната диагностика и навременното лечение са ключови за избягване на тежки усложнения.
Ямбол също е в предепидемична ситуацията. Здравните власти започнаха проверки. Спазва ли се сутрешният филтър в детските заведения – гледайте във видеото:
По материала работиха Каролина Занкова и Дани Атанасова.
Последвайте ни за още актуални новини в Google News Showcase
Последвайте btvnovinite.bg във VIBER
Последвайте btvnovinite.bg в INSTAGRAM
Последвайте btvnovinite.bg във FACEBOOK
Последвайте btvnovinite.bg в TIKTOK